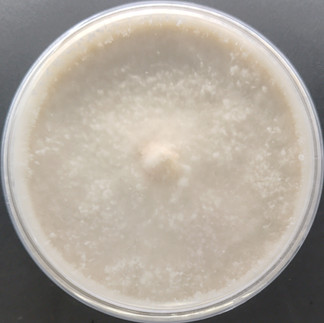

Agripie's Latest News and Updates
- Neeraj Kumar
- Oct 9, 2025
- 2 min read
Updated: Dec 22, 2025
This page presents the latest news and update at out lab.
09 Oct 2025: New batch of Pure Cultures of Mushroom
06 October 2025: Optimization of Culture Vessel Design for Cordyceps militaris Cultivation
I provided Cordyceps militaris cultivation training to Mr. Canny in Shimla on 28 Aug - 01 Sep 2025.
Besides other improvements, the change in design of culture vessel was also suggested. He was using a 4 inch (dia) and 3.5 inch (height) plastic, food grade vessels to cultivate Cordyceps. It worked for him as only a few fruiting body reached the top cap after 55-65 days of incubation.

The optimum height of Cordyceps culture vessel is 5-6 inches.
The below images are from his lab, Cordyceps in these boxes are 30 days old. Some of the fruiting bodies have already reached the length of 2 - 2.5 inches, reaching thee top lid. So, there's not enough vertical space for Cordyceps growth for another one month.
After observing this growth, he proceed to buy 5.5 inches deep boxes (similar shape and material) for future batches.
So, the Cordyceps cultivators are shall choose a culture vessel with a depth of 5-6 inches to accommodate the vertical growth of Cordyceps during the incubation period of 54-65 days (besides some other characteristics of the culture vessel).
After our training: Cordyceps militaris growth after 30 days of incubation
After our training: Cordyceps militaris growth after 45 days of incubation
After our training: Cordyceps militaris harvesting at day 51 since incubation
22-24 September 2025: Training on Commercial Cultivation of Cordyceps militaris
Mr. Ram Bhawan, Mau, UP [ A retired engineer, Indian Railways]

15-21 September 2025: Training on Commercial Cultivation of Cordyceps militaris at Bengaluru
24-26 August 2025: Arogya Utsav & Expo 2025
February 2025: Cordyceps Training to a Team from Pune
January 2025: At DMR Solan
March 2024: 11th Bihar Entrepreneurship Summit 2024
February 2024: ICAR- RCER Foundation Day, 22 February 2024 Patna, Bihar.

Comments